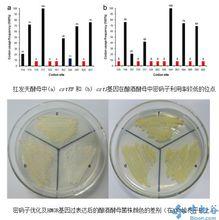
番茄紅素β-環化酶

定義
 番茄紅素β-環化酶
番茄紅素β-環化酶 番茄紅素 β-環化酶(LCYB)是類胡蘿蔔素合成途徑中中的關鍵酶,在番茄紅素 β-環化酶的催化下,番茄紅素可轉化合成 β-胡蘿蔔素。
番茄紅素的環化反應可使番茄紅素轉化生成δ-胡蘿蔔素和β-胡蘿蔔素,這是藻類體內生產具有重要生理功能的β-胡蘿蔔素的重要反應,因此,研究該酶非常重要。植物體記憶體在兩種番茄紅素環化酶,其分別為番茄紅素ε-環化酶(LycE)和番茄紅素β-環化酶(LycB)。其中,番茄紅素ε-環化酶(LycE)的催化產物為δ-胡蘿蔔素,番茄紅素的一個末端發生δ-環化;而番茄紅素β-環化酶(LycB)的催化產物為β-胡蘿蔔素,番茄紅素兩個末端都發生了β-環化。研究番茄紅素β-環化酶的基因調控及該酶的功能催化機理,可以解釋為什麼杜氏藻內可以生產並積累細胞內含物總量1/6的β-胡蘿蔔素。
基因
番茄紅素β-環化酶
番茄紅素β-環化酶 LYCB基因最早從擬南芥中克隆得到。隨後從辣椒、番茄、菸草和黃水仙中分離到,其cDNA長1.6~2.Okb編碼498-503個胺基酸。己分離到ε環化酶基因的植物有擬南芥和番茄,其cDNA分別長1.9~2.7kb,分別編碼524和526個胺基酸。Kato等對不同柑橘品種類胡蘿蔔素積累和生物合成基因表達進行研究,表明在柑橘果實成熟時Lcyb表達增強,Lcye表達消失,同時帶β環玉米黃素和繭菜黃素大量增加。而Pecke等發現在番茄果實成熟期,zcyb和Lcye的表達消失。
1995年,在以擬南芥為實驗材料的研究中,首次分離得到LycB基因,在之後的研究中,在辣椒、番茄、菸草等植物中也依次分離到該基因。2006年,陶俊等從枇杷中分離到番茄紅素β-環化酶基因片段;張建成等從紅肉臍橙中克隆到了β-環化酶基因片段;陳一明等分離得到龍膽草中的LycB基因;LycB基因也套用於轉基因工程技術中,梁燕等以菸草細胞為受體細胞,從胡蘿蔔獲得番茄紅素β-環化酶的反義RNA並將該基因轉化,結果發現,與未轉化胡蘿蔔相比,轉化胡蘿蔔株組織中的胡蘿蔔素含量相對較高。但是,在這些研究中,分離得到的大多為cDNA序列,對基因組序列及其側翼序列尤其啟動子序列的報導很少。
LycB基因與β-胡蘿蔔素的生產直接相關,因此,克隆該基因,是非常有意義的。一方面,是類胡蘿蔔代謝途徑分子水平研究的一個組成部分,是綜合研究胡蘿蔔素代謝分子機制的一分子;另一方面,為從本質上解釋杜氏藻積累豐富營養物質的分子機制、耐鹽分子機制等研究,奠定了基礎。
研究意義
 番茄紅素β-環化酶
番茄紅素β-環化酶 充分成熟的柑桔果實中主要呈色色素是類胡蘿蔔素。類胡蘿蔔素的含量及組成影響柑桔果實的色澤,繼而影響品質和商品價值。類胡蘿蔔素作為光合作用的輔助色素,參與光保護,清除活性氧,還是ABA和某些芳香物質的前體。不少類胡蘿蔔素可轉化為維生素A為人體利用,多數類胡蘿蔔素具有清除活性氧和抗癌作用,因此柑桔果實的類胡蘿蔔素含量及組.成也影響了其保健價值。人們一直對類胡蘿蔔素代謝途徑十分關注,但由於該代謝的複雜性,直到上個世紀末,植物類胡蘿蔔素合成代謝主鏈上的成員及其關鍵酶和基因才得到闡明。
β-胡蘿蔔素和番茄紅素是最早也是至今最受關注的兩種類胡蘿蔔素,前者可在人體內轉變成維生素A,後者是所有類胡蘿蔔素中抗氧化能力最強、顏色最紅的,並對多種癌症的發生和發展有抑制作用。然而,番茄紅素除了在相桔紅色芽變品種中高含量存在外,在其他相桔中均不存在,β一胡蘿蔔素也通常不是柑桔的主要類胡蘿蔔素。多數相桔果實類胡蘿蔔素以葉黃素類為主(可占類胡蘿蔔素總量的80%)。發生色澤變化的天然柑桔突變體有不少,但較為出名的一類是導致番茄紅素積累的相桔紅色突變體。未發生突變的相桔果實中通常不能檢測出番茄紅素,而有些紅色突變體中番茄紅素可以成為最主要的類胡蘿蔔素。除了番茄紅素積累,紅色突變體都有p胡蘿蔔素的積累。常見的積累番茄紅素的柑桔種類有Fastez粉紅葡萄柚,Marsll粉紅葡萄柚,Ruby紅葡萄柚,Brtlgundy紅葡萄柚,Cara Cara紅肉臍橙。
番茄紅素在LCYb,催化下轉變成β-胡蘿蔔素,在LCYb和番茄紅素。環化酶協同作用下轉變成β一胡蘿蔔素,卜一α-胡蘿蔔素是合成途徑中最先生成的具環狀的類胡蘿蔔素。但紅肉臍橙等突變體積累番茄紅素是否與該基因突變有關尚無報導。徐昌傑等根據植物番茄紅素β-環化酶基因的保守區序列設計PCR,對甜橙基因組DNA入噬菌體文庫進行PcR篩選(退火溫度為52℃)獲得甜橙番茄紅素β環化酶同源基因。結合亞克隆及RAPD結果共獲得2027bp序列,包括完整編碼區,不含內含子,編碼504個胺基酸。後續研究表明甜橙中存在兩個不同序列的番茄紅素β環化酶等位基因。
套用
由於番茄果實發育過程中顏色變化比較大並且果實當中含有豐富的番茄紅素和β-胡蘿蔔素因而被認為是進行研究園藝植物類胡蘿蔔素代謝途徑的模式植物。將外源PSY基因轉入番茄中,通過外源基因的表達,以提高番茄中類胡蘿蔔素含量。1995年,Fray等將番茄的PSY基因正義導入番茄,導致轉化植株表現出矮化、類胡蘿蔔素異常合成等多種不良效應。而之後,2000年,Rosati等將擬南芥的LCYB基因轉化番茄果實,該基因的特異性過達導致番茄果實中β-胡蘿蔔素含量增加7倍,而類胡蘿蔔素的總含量基本不變有提高。2002年,Fraser等用人工構建的啟動子和番茄結合,將八氫番茄紅素合成酶(PSY)基因在番茄果實特異性啟動子驅動下導入番茄,轉基因番茄植株中的類胡蘿蔔素含量較野生型番茄增加了2-4倍,番茄紅素、β-胡蘿蔔素和葉黃素含量也有很大提高。這種果實特異表達的PSY基因,提高了番茄果實中營養價值較高的類胡蘿蔔素含量,為今後類胡蘿蔔素基因工程研究奠定了基礎。
水稻種子胚乳可自身合成GGPP,但不能合成類胡蘿蔔素。因此利用常規的育種技術無法培育出胚乳中含有類胡蘿蔔素的水稻品種。在世界最貧窮的人口中,由於維生素A缺乏導致每年50萬人失明和100萬人死亡。將類胡蘿蔔素合成的關鍵酶基因導入水稻,使其在胚乳中表達,並提高胚乳中類胡蘿蔔素的含量,可以有效緩解維生素A缺乏症。1997年Burkhardt等用基因槍法將黃水仙的PSY基因正義導入水稻。經檢測,在轉基因水稻種子的內胚乳中發現有八氫番茄紅素的積累。 Yex等2000年將黃水仙的PSY和LCYE以及歐文氏菌(Erwiolauredovora)的Crtl基因三個基因一起轉入到一口本水稻品種,結果獲得了胚乳呈黃色的“金色水稻”,種子中含有β-胡蘿蔔素(部分種子的類胡蘿蔔素含量達到了1.6μg/g Dw),此外還含有大量的玉米黃素、葉黃質。轉基因“金色水稻”就是為了應對維生素A缺乏症而生的。如今“金色水稻”己被捐贈給設在菲律賓的國際水稻研究所,用於開發富含β-胡蘿蔔素的水稻新品種。2005年,Paine等將玉米PSYb基因導入水稻,得到了第二代“黃金水稻”,其類胡蘿蔔素含量高達37μg/g (Dw),並且進一步證實了PSY基因是水稻類胡蘿蔔素合成的關鍵酶基因。

